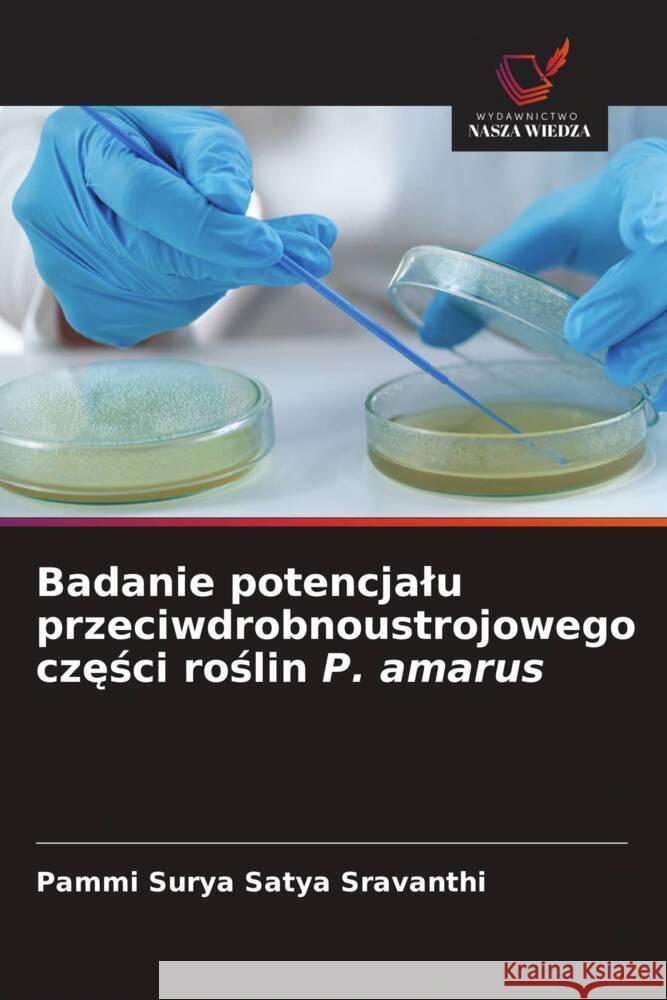
Badanie potencjalu przeciwdrobnoustrojowego czesci roslin P. amarus Surya Satya Sravanthi, Pammi 9786137363065

topmenu
Wyniki wyszukiwania:
wyszukanych pozycji: 12
 |
Exploração do potencial antimicrobiano das partes da planta P. amarus
ISBN: 9786137363089 / Portugalski / Miękka / 2025 / 96 str. Termin realizacji zamówienia: ok. 10-14 dni roboczych. |
cena:
272,40 |
 |
Esplorazione del potenziale antimicrobico delle parti vegetali di P. amarus
ISBN: 9786137363058 / Włoski / Miękka / 2025 / 96 str. Termin realizacji zamówienia: ok. 10-14 dni roboczych. |
cena:
272,40 |
 |
O poder curativo do Phyllanthus amarus
ISBN: 9786208709297 / Portugalski / Miękka / 2025 / 52 str. Termin realizacji zamówienia: ok. 16-18 dni roboczych. |
cena:
195,29 |
 |
Die heilende Kraft von Phyllanthus amarus
ISBN: 9786208709242 / Niemiecki / Miękka / 2025 / 56 str. Termin realizacji zamówienia: ok. 16-18 dni roboczych. Pflanzen sind wichtige Bestandteile der Natur und überall auf der Welt leicht verfügbar. Der Schöpfer könnte also alle Krankheiten auf natürliche Weise durch diese Pflanzen in Form von Arzneimitteln geheilt haben. Die Kräutermedizin hat ihren Ursprung in prähistorischer Zeit, und diese Informationen wurden über Generationen weitergegeben. Die Bedeutung der Forschung mit Heilpflanzen hat in den letzten zehn Jahren stark zugenommen, um neue Phytopharmaka zu entwickeln. Pflanzliche Arzneimittel werden in der Regel bei langwierigen Krankheiten eingesetzt, da sie weniger Nebenwirkungen...
Pflanzen sind wichtige Bestandteile der Natur und überall auf der Welt leicht verfügbar. Der Schöpfer könnte also alle Krankheiten auf natürliche...
|
cena:
195,29 |
|
Badanie potencjalu przeciwdrobnoustrojowego czesci roslin P. amarus
ISBN: 9786137363065 / Polski / Miękka / 2025 / 96 str. Termin realizacji zamówienia: ok. 10-14 dni roboczych. |
cena:
272,40 |
 |
Erforschung des antimikrobiellen Potenzials von P. amarus-Pflanzenteilen
ISBN: 9786137363010 / Niemiecki / Miękka / 2025 / 100 str. Termin realizacji zamówienia: ok. 10-14 dni roboczych. Sekundäre Pflanzenstoffe haben sich aufgrund ihrer vielfältigen biologischen Eigenschaften, darunter antivirale, antibakterielle, antioxidative und krebsbekämpfende Wirkungen, als unschätzbare Quelle für Arzneimittel erwiesen. Sekundäre Pflanzenstoffe sind einzigartige Quellen für Arzneimittel, Lebensmittelzusatzstoffe, Aromastoffe und andere industrielle Anwendungen. Die kommerzielle Bedeutung dieser Sekundärmetaboliten hat in den letzten Jahren zu einem großen Interesse an der Erforschung ihrer Möglichkeiten geführt. Terpenoide, Alkaloide, Phenole und Flavonoide sind einige der...
Sekundäre Pflanzenstoffe haben sich aufgrund ihrer vielfältigen biologischen Eigenschaften, darunter antivirale, antibakterielle, antioxidative und ...
|
cena:
272,40 |
 |
Le pouvoir de guérison de Phyllanthus amarus
ISBN: 9786208709259 / Francuski / Miękka / 2025 / 56 str. Termin realizacji zamówienia: ok. 16-18 dni roboczych. Les plantes sont des éléments importants de la nature et sont facilement disponibles dans le monde entier. Il est donc possible que le créateur ait donné des remèdes à toutes les maladies de manière naturelle par l'intermédiaire de ces plantes sous la forme de médicaments. Les plantes médicinales trouvent leur origine dans la période préhistorique et cette information a été transmise de génération en génération. Le rôle de la recherche sur les plantes médicinales s'est accru rapidement au cours de la dernière décennie pour le développement de nouveaux produits...
Les plantes sont des éléments importants de la nature et sont facilement disponibles dans le monde entier. Il est donc possible que le créateur ait...
|
cena:
195,29 |
 |
Uzdrawiajaca moc Phyllanthus amarus
ISBN: 9786208709266 / Polski / Miękka / 2025 / 52 str. Termin realizacji zamówienia: ok. 16-18 dni roboczych. |
cena:
195,29 |
 |
Exploration du potentiel antimicrobien des parties de la plante P. amarus
ISBN: 9786137363041 / Francuski / Miękka / 2025 / 100 str. Termin realizacji zamówienia: ok. 10-14 dni roboczych. Les métabolites secondaires des plantes se sont révélés être une source inestimable de produits pharmaceutiques grâce à leurs diverses propriétés biologiques, notamment leurs effets antiviraux, antibactériens, antioxydants et anticancéreux. Les métabolites secondaires sont des sources uniques pour les produits pharmaceutiques, les additifs alimentaires, les arômes et d'autres applications industrielles. L'importance commerciale de ces métabolites secondaires a suscité un grand intérêt pour l'exploration de leurs possibilités ces dernières années. Les terpénoïdes, les...
Les métabolites secondaires des plantes se sont révélés être une source inestimable de produits pharmaceutiques grâce à leurs diverses proprié...
|
cena:
272,40 |
 |
Exploration of Antimicrobial potential of P. amarus plant parts
ISBN: 9786208462765 / Angielski / Miękka / 2025 / 108 str. Termin realizacji zamówienia: ok. 10-14 dni roboczych. Plant secondary metabolites have proven to be an invaluable source of pharmaceuticals with their varied biological properties viz. antiviral, antibacterial, antioxidant and anticancer effects. Secondary metabolites are unique sources for pharmaceuticals food additives, flavors and others industrial values. Commercial importance of these secondary metabolites has resulted in a great interest in exploring possibilities in the recent years. Terpenoids, alkaloids, phenolics and flavonoids are some of the bioactive compounds that contribute to the medicinal value of a plant. Phyllanthus amarus...
Plant secondary metabolites have proven to be an invaluable source of pharmaceuticals with their varied biological properties viz. antiviral, antibact...
|
cena:
272,40 |
 |
The Healing Power of Phyllanthus amarus
ISBN: 9786208428372 / Angielski / Miękka / 2025 / 52 str. Termin realizacji zamówienia: ok. 16-18 dni roboczych. Plants are significant components of nature and are easily available all over the globe. So, creator might have given remedies for all diseases naturally through these plants in the form of drugs. Herbal medicine had their source since pre-historic period and that information has been passed over generations. Role of research using herbs of medicinal importance is increasing rapidly during the preceding decade for development of new phytopharmaceuticals. Herbal medicines are generally used for long-standing diseases keeping in view our safety as they have fewer side effects. This is an era...
Plants are significant components of nature and are easily available all over the globe. So, creator might have given remedies for all diseases natura...
|
cena:
195,29 |
 |
Il potere curativo del Phyllanthus amarus
ISBN: 9786208709280 / Włoski / Miękka / 2025 / 52 str. Termin realizacji zamówienia: ok. 16-18 dni roboczych. |
cena:
195,29 |










